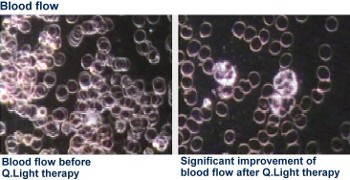
Efekt nawietlania Q.Light

Bezbolesne leczenie ran światłem Q.Light®

Światłoterapia Q.Light® stosowana jest zarówno do leczenia ran przewlekłych, trudno gojących się, może być również stosowana profilaktycznie.
Główne zastosowanie światła Q.Light® w leczeniu ran:
- * Owrzodzenia żylakowate podudzi
- * Odleżyny
- * Stopa cukrzycowa
- * Rany pooperacyjne
- * Rany pourazowe
- * Oparzenia
- * Bliznowce
Efektywność biologiczna:
Bezbolesne leczenie ran światłem Q.Light® wspiera mikrocyrkulację oraz bierze udział w każdym z etapów gojenia ran przyczyniając się do szybszych i lepszych efektów leczniczych. Działa przeciwzapalnie i przeciwbólowo, aktywuje obronę immunologiczną, zwiększa perfuzję tkankową i przyspiesza podział komórek krwii.
Taki efekt leczniczy jest możliwy dzięki dwóm modułom leczniczym Q.Light® WOUND CARE, jeden z spektrum 385-780 nm i drugim ze spektrum 385-1700 nm. Światło spolaryzowane posiada gęstość 40 mW/cm2. Q.Light® WOUND CARE może być łatwo łączony z innymi metodami leczenia dlatego jest interesującą i wartościową metodą leczniczą.
Leczenie ran światłem Q.Light może odbywać się za pomocą specjalistycznej lampy
Q.Light WOUND CARE
lub lampami:
Copyright 2004 - 2010 Tantum Sp.J.